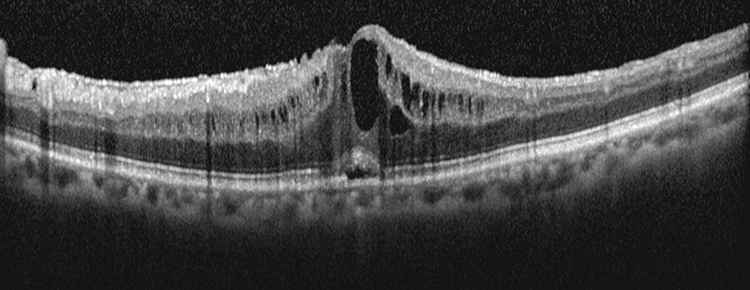
Rapuano9781975243722-ch011_f027.jpg

(See Figures 11.14.1 to 11.14.3.)
Figure 11.14.1: Cystoid macular edema.

Figure 11.14.2: Intravenous fluorescein angiography of cystoid macular edema.

Figure 11.14.3: Optical coherence tomography of cystoid macular edema.

Critical
Irregularity and blunting of the foveal light reflex, macular thickening with or without small intraretinal cysts in the foveal region.
Other
Vitreous cells, optic nerve swelling, and dot hemorrhages may be observed depending upon etiology of CME.
Treat the underlying disorder if possible. For CME related to specific etiologies (e.g., diabetes, RVO, intermediate uveitis, etc.), see specific sections.
Topical NSAID (e.g., ketorolac 0.5% q.i.d., bromfenac 0.09%, or nepafenac 0.3% daily) often in conjunction with topical steroids (e.g., prednisolone acetate 1% q.i.d.).
Discontinue topical epinephrine, dipivefrin, or prostaglandin analog drops and medications containing nicotinic acid.
Other forms of therapy are often used to treat CME depending upon etiology:
Subtenon steroid (e.g., triamcinolone 40 mg/mL, inject 0.5 to 1.0 mL).
Intravitreal steroid (e.g., triamcinolone 40 mg/mL, inject 1 to 4 mg).
Suprachoroidal steroid (e.g., triamcinolone 4 mg/0.1 mL)
Intravitreal anti-VEGF therapy (e.g., bevacizumab 1.25 mg in 0.05 mL).
Systemic steroids (e.g., prednisone 40 mg p.o. daily for 5 days and then taper over 2 weeks).
Systemic NSAIDs (e.g., indomethacin 25 mg p.o. t.i.d. for 6 weeks).
Topical or systemic carbonic anhydrase inhibitors (e.g., dorzolamide 2% t.i.d. or acetazolamide 500 mg p.o. daily starting dose) in cases of RP-associated CME.
CME with or without vitreous incarceration in a surgical wound may be improved by vitrectomy or YAG laser lysis of the vitreous strand.
Postsurgical CME patients should be started on a topical NSAID and a topical steroid with follow-up in 4 to 6 weeks to determine response to topical drop therapy. Other forms of CME should be followed in a similar time frame to monitor response to initial therapy.